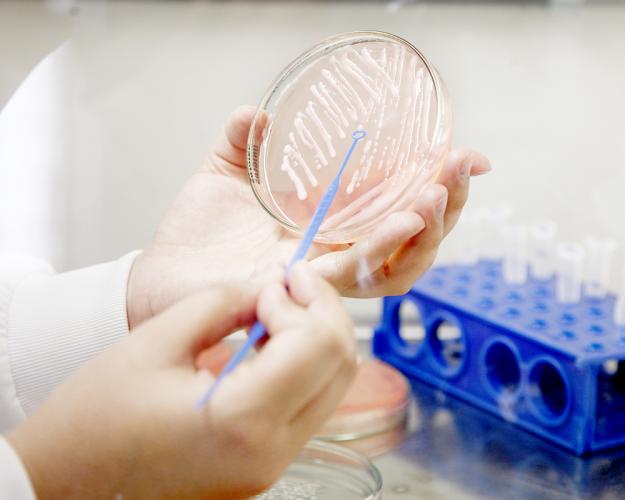
.

Pesquisa da UEPG identifica nova espécie de bactéria no Canyon Guartelá 10/10/2019 - 15:45
Uma pesquisa do Mestrado em Biologia Evolutiva da UEPG, realizada no Laboratório de Biodiversidade, em parceria com o Laboratório de Tecnologia do Solo da Embrapa, identificou uma nova espécie de bactéria fixadora de nitrogênio. A espécie Paraburkholderia guartelanensis foi nomeada em homenagem ao Parque Estadual do Guartelá, onde foi encontrada. A bactéria foi isolada de nódulos na raiz da planta leguminosa Mimosa gymnas, nativa do parque.
O artigo foi apresentado no 30º Congresso Brasileiro de Microbiologia, em Maceió-AL, e foi premiado como o melhor trabalho na área Coleções de Culturas e Taxonomia. A premiação aconteceu nesta quarta (09), durante o encerramento do evento, promovido pela Sociedade Brasileira de Microbiologia.
A dissertação de Fabiane Paulitsch, uma das autoras da descoberta, teve como objetivo identificar os rizóbios simbiontes das plantas nativas do Parque Estadual do Guartelá. O estudo indicou que possivelmente se tratava de uma nova espécie, como conta a professora Jesiane Batista, orientadora da dissertação e coordenadora do laboratório de Biodiversidade. “Analisando os simbiontes da espécie vegetal Mimosa gymnas, verificamos que as bactérias eram muito diferentes das espécies descritas até então. Agora, em sua tese de doutorado em Microbiologia, a discente confirmou que a planta é colonizada por uma nova espécie”, relata.
Iniciando como um estudo exploratório, sem busca específica por novas espécies, a coleta de microorganismos do solo do parque já conseguiu identificar, em resultados preliminares, a existência de outras quatro novas espécies de rizóbios, também isoladas de plantas nativas dos Campos Gerais pelo Laboratório de Biodiversidade. “A elevada diversidade biológica característica da região, usualmente relatada em levantamentos de fauna e flora, também se aplica aos microorganismos”, aponta a professora.
O Parque Estadual do Guartelá é considerado um ambiente rico em biodiversidade. Localizado no município de TIbagi, nos Campos Gerais, tem cerca de 800 hectares de área, protegendo o patrimônio natural e arqueológico da região do canyon do Rio Iapó.
Importância ambiental
As bactérias fixadoras de nitrogênio são elementos ecológicos fundamentais para a sustentabilidade dos ecossistemas. “As comunidades microbianas são componentes fundamentais de ecossistemas e possuem um papel crucial na ciclagem da matéria orgânica e transformações biogeoquímicas dos elementos. Nesse contexto, destaca-se a fixação biológica de nitrogênio, um processo exclusivamente realizado por bactérias, que permite a transformação do nitrogênio molecular (que corresponde a cerca de 80% do ar
atmosférico) em formas passíveis de assimilação por espécies vegetais e consequente incorporação desse nutriente aos ecossistemas”, destaca Jesiane.
Essas bactérias são responsáveis por uma porção considerável do nitrogênio adquirido pelas plantas, variando de acordo com a espécie vegetal e condições ambientais. Quando aliadas às plantas leguminosas, as bactérias fixadoras de nitrogênio têm um grande impacto na incorporação desse elemento ao ecossistema. Essa é, segundo a professora, a interação que permite maior aporte de nitrogênio para o hospedeiro.
A bactéria Paraburkholderia guartelanensis está sendo caracterizada por estudos do Mestrado em Biologia Evolutiva. “Além de ser fixadora de nitrogênio e ter pronunciada tolerância a estresses abióticos, verificamos que a mesma possui capacidade de solubilização de fosfato e produção de hormônios vegetais”, antecipa a professora.
Sobre a pesquisa
O estudo é resultado de uma parceria entre o Laboratório de Biodiversidade da UEPG e o Laboratório de Biotecnologia do Solo da Embrapa Soja. A descoberta foi publicada na revista científica Archives of Microbiology, em artigo que pode ser acessado neste link.